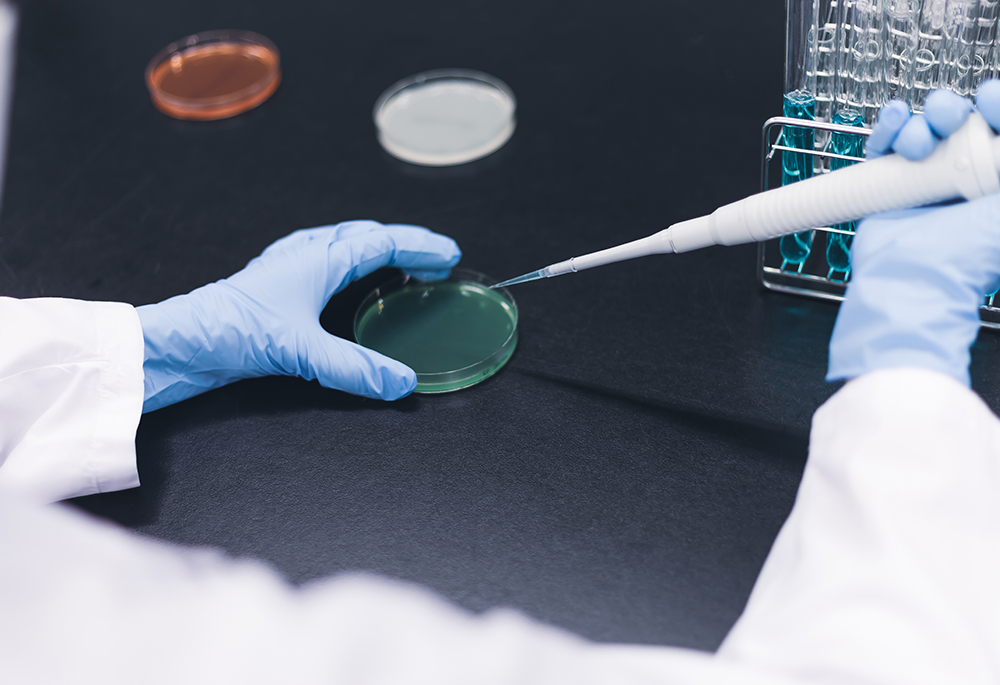

水質検査
- 茨城県薬剤師会検査センター TOP
- 水質検査
その他の水質検査について
多種多様な水質検査
当社では、飲料水以外にもプール水、浴槽水、クーリングタワー(冷却塔)の水、食品製造用水等、幅広く検査を行っています。
また、水道施設の技術的基準(薬品、資機材等)の検査や、給水装置の構造及び材質についての浸出性能試験、クリプトスポリジウム検査等、水道水質基準項目以外も受託可能です。
お客様に合わせた検査のご提案も可能ですので、一度お問い合わせください。

IPICの水質検査が選ばれる理由
-
Point 01
幅広い検査内容に対応
お客様のご要望に合わせた検査を実施できるよう、多種多様な検査機器を取り揃えるとともに、経験豊かな検査員による検査体制を構築しております。
-
Point 02
長年の経験と実績
創業から50年以上にわたる検査の経験と実績をもとに、お客様へのアドバイスを行います。
-
Point 03
ご要望があればご相談ください
〇〇の検査だけを行いたい、△△までに結果が必要など、お客様それぞれのご要望にできる限り対応いたしますので、一度ご相談ください。
水道水に関する各種検査のご紹介
プール水検査
学校プール水については「学校保健安全法」における学校環境衛生基準に基づいた検査、遊泳用プール水については厚生労働省が定める「遊泳用プールの衛生基準に基づいた検査」が義務づけられています。

学校プール水検査
水質検査は、使用日の積算が30日以内ごとに1回行います。
ただし、総トリハロメタンについては使用期間中の適切な時期に1回以上、循環ろ過装置の処理水については毎学年1回定期に検査を行います。
検査対象施設
幼稚園、小学校、中学校、義務教育学校、高等学校、中等教育学校、特別支援学校、大学、盲学校、聾学校、高等専門学校といった学校教育法第1条に規定される学校に設置されているプールが対象です。
一般遊泳用プール水検査
水質検査は、毎月1回以上行います。
ただし、総トリハロメタンについては毎年1回以上検査を行います。
遊泳用プールとは
多数の人に水泳させる施設のうち、学校に設置されるプールを除いたもので、おおむね100立法メートル以上のものが対象ですが、プール本体の水の容量の合計が100立法メートルに満たないものであってもこれらの基準に合致することが望ましく、幼少児が多数利用するものについては特に配慮が必要です。
試料採水地点
長方形のプールでは、プール内の対角線上におけるほぼ等間隔の位置3箇所以上の水面下20cm及び循環ろ過装置の取入口付近を原則とします。
A点B点及びC点またはD点B点及びE点の3点に循環ろ過水の取入口を加えた4点を最低限の採水地点とする。
その他の形状のプールでは、これに準じ、プールの形状に応じた適切な地点で採水します。

浴槽水水質検査
浴槽を設置している施設では、多数の人が浴槽を出入りすることにより、常に浴槽に汚れが持ち込まれる状況になります。そのため、循環式ろ過機や滅菌装置等の設備が適切に稼働していることや、適切な頻度での清掃が重要です。
茨城県では、旅館業法及び公衆浴場法施行条例の中で、入浴施設の衛生措置基準が定められています。
当社では、条例などで定められた水質基準に該当するレジオネラ属菌等の水質検査を行っています。

給水設備について
給水設備は厚生労働省告示第264号により、貯湯槽の滞留水を定期的に排水する必要があります。1年に1回以上、清掃を実施することで、浴槽水水質検査の義務はございません。
| 循環式浴槽 | 循環式ろ過機によって浴槽水を浄化することができる機能を有する浴槽を循環式浴槽という。循環式浴槽は湯水の節約を行うため、ろ過機を中心とする設備、湯水を再利用するため一時的に貯留する槽(タンク)及びそれらの設備をつなぐ配管を伴い、複雑な循環系を構成することが多くなっている。これら設備の衛生管理、構造設備上の措置を十分行う必要がある。 |
|---|---|
| 公衆浴場 | 公衆浴場とは、温湯・潮湯・温泉等を使用して同時に多数人を入浴させる浴場をいう。 |
| 旅館 | 旅館にある浴槽施設をいう。ただし、客室に設置された入浴施設で利用者が浴槽の湯水を取り替えることのできるものについては、適用しない。 |
| 原湯 | 浴槽の湯を再利用せず、浴槽に直接注入される温水をいう。 |
| 原水 | 原湯の原料に用いる水及び浴槽の水の温度を調節する目的で、浴槽の水を再利用せず浴槽に直接注入される水をいう。 |
| 上がり用湯 | 洗い場及びシャワーに備え付けられた湯栓から供給される温水をいう。 |
| 上がり用水 | 洗い場及びシャワーに備え付けられた水栓から供給される水をいう。 |
食品に使用する水の水質検査
安心・安全のために、年1回の水質検査をしませんか?
食品の製造や調理に水道水以外の水を使用している場合は、その使用している水の水質検査が必要になる場合があります。水道水は、定期的に供給者側で水質検査を行っていますが、水道水以外の水は自らが検査を行わなければ水質はわかりません。当社では、食品衛生法等に準拠した水質検査を行います。

食品営業許可申請に必要な水質検査
食品の製造や販売、飲食店の営業許可申請を行う際に水道水以外の水を使用する施設は、水質検査が必要になる場合があります。
詳しくは、保健所へお問い合わせください。
特に新規の営業許可申請や営業設備の変更については、お早めにお問い合わせください。
食品に使用する水の水質検査
-
STEP1
ご相談・お申し込み
お申し込みいただいた後に、お電話やメールで検査内容についての打合せをさせていただきます。 -
STEP2
検査容器貸し出し
当社、各保健所内食品衛生協会、一部市町村等で貸し出しを行っております。
※当社職員による採水の場合は、容器は職員が持参します。 -
STEP3
採水・ご提出(当日)
ご依頼当日に採水の後、名前を記入したラベルを容器に直接貼り、その日のうちに依頼書とサンプルの入った容器をご提出ください。 -
STEP4
検査結果郵送
12項目の検査に、1週間ほどお時間をいただいております。基準値を超えた場合、速報にてご連絡し、再検査実施のご相談もさせていただいております。
その他の水質検査
水道施設の技術的基準
「水道施設の技術的基準を定める省令」に基づいた、水道施設の技術的基準(薬品や資機材等)に係る検査や給水装置の構造及び材質についての浸出性能試験等も行っております。
クリプトスポリジウム検査
クリプトスポリジウムは、胞子虫類のコクシジウム目に属する寄生性原虫です。
原虫による感染症で、世界中でみられる病気です。衛生設備・下水設備が整っていない地域での食事や飲水、水泳などをした人は、感染のリスクが高くなります。
動物に感染するものに、胃に寄生する大型種(Cryptosporidium muris/オーシストの大きさ;6.6~7.9×5.3~6.5μm)と、ヒトの小腸の上皮細胞に寄生する小型種(Cryptosporidium parvum/オーシストの大きさ;4.5~5.4×4.2~5.0μm)とがあります。寄生し増殖したオーシストはやがて糞便とともに外界へ排泄されて、水や食品を介して新たな宿主のもとで感染を起こします。また、C. parvumは広い範囲の哺乳動物に感染することが確認されています。
免疫の正常な人が罹患した場合の症状は、下痢(主に水様下痢)、腹痛、倦怠感、食欲低下などであり、軽度の発熱を伴うこともあります。潜伏期間は3~10日で、下痢は1日数回程度から20回以上の激しいものまで多様です。症状は数日から2~3週間続いた後、自然治癒します。しかし、幼児や高齢者、免疫不全者は症状が重くなることがあり、有効な治療法がないので、特に注意が必要です。

レジオネラ属菌検査
レジオネラ属菌は本来、土壌・河川水・湖等の自然界に広く分布している自然環境中の常在菌ですが、一般にその数は少ないと考えられています。
しかし、冷却塔水や循環器浴槽には原生動物が多く生息するため、これらの細胞にとりこまれたレジオネラ属菌は増殖を続けます。レジオネラ属菌は、人の気道に感染するため、レジオネラ属菌を含むエアロゾルを介して人に感染し、肺炎などのレジオネラ症を引き起こす原因にもなります。
レジオネラ肺炎には健常者もかかりますが、弱小者、高齢者、免疫不全者などがかかりやすい傾向にあります。
クーリングタワーについて
厚生労働省の出している「建築物における維持管理マニュアル」では、「冷却塔及び冷却水の維持管理方法」の中で、「レジオネラ属菌検査の状況およびその結果を調べ、記録する。」としています。また、要注意対象の冷却塔に関しては、必要に応じてレジオネラ属菌検査を行うなど、冷却水の洗浄・殺菌効果を確認する一つの目安としています。
また、「レジオネラ症を予防するために必要な措置に関する技術上の指針」では、レジオネラ属菌検査には触れていませんが、「汚れの状況を点検し、必要に応じ、清掃・換水等を実施すること」などが盛り込まれ、冷却塔でのレジオネラ属菌の繁殖への注意を促しています。

検査依頼の流れ
-
STEP1
ご相談・お申し込み
お申し込みいただいた後に、お電話やメールで検査内容についての打合せをさせていただきます。 -
STEP2
検査容器貸し出し
当社、各保健所内食品衛生協会、一部市町村等で貸し出しを行っております。
※当社職員による採水の場合は、容器は職員が持参します。 -
STEP3
採水・ご提出(当日)
ご依頼当日に採水の後、名前を記入したラベルを容器に直接貼り、その日のうちに依頼書とサンプルの入った容器をご提出ください。 -
STEP4
検査結果郵送
およそ2週間で、検査結果を郵便でお送りします。





